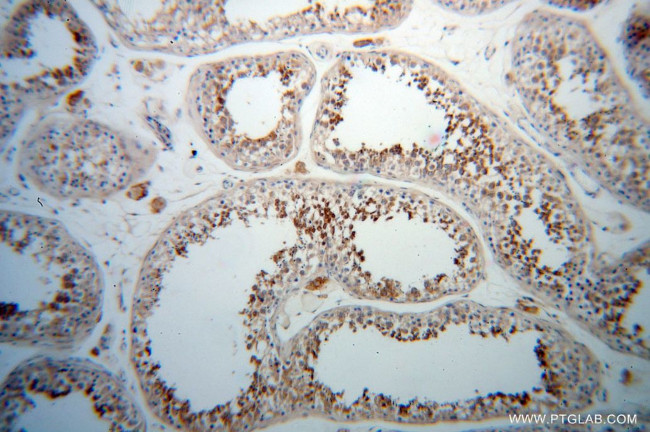
PABPC3 Antibody in Immunohistochemistry (Paraffin) (IHC (P))

Search
Proteintech
PABPC3 Polyclonal Antibody
{{$productOrderCtrl.translations['antibody.pdp.commerceCard.promotion.promotions']}}
{{$productOrderCtrl.translations['antibody.pdp.commerceCard.promotion.viewpromo']}}
{{$productOrderCtrl.translations['antibody.pdp.commerceCard.promotion.promocode']}}: {{promo.promoCode}} {{promo.promoTitle}} {{promo.promoDescription}}. {{$productOrderCtrl.translations['antibody.pdp.commerceCard.promotion.learnmore']}}
产品信息
12625-2-AP
种属反应
已发表种属
宿主/亚型
分类
类型
抗原
偶联物
形式
浓度
规格
纯化类型
保存液
内含物
保存条件
运输条件
产品详细信息
Immunogen sequence: MNPSTPSYP TASLYVGDLH PDVTEAMLYE KFSPAGPILS IRICRDLITS GSSNYAYVNF QHTKDAEHAL DTMNFDVIKG KPVRIMWSQR DPSLRKSGVG NIFVKNLDKS INNKALYDTV SAFGNILSCN VVCDENGSKG YGFVHFETHE AAERAIKKMN GMLLNGRKVF VGQFKSRKER EAELGARAKE FPNVYIKNFG EDMDDERLKD LFGKFGPALS VKVMTDESGK SKGFGFVSFE RHEDAQKAVD EMNGKELNGK QIYVGRAQKK VERQTELKRT FEQMKQDRIT RYQVVNLYVK NLDDGIDDER LRKAFSPFGT ITSAKVMMEG G (1-330 aa encoded by BC027617)
靶标信息
Messenger RNA stability and translation initiation are extensively under the control of poly(A)-binding proteins (PABP). See PABPC1 (MIM 604679) for background information.
仅用于科研。不用于诊断过程。未经明确授权不得转售。
生物信息学
蛋白别名: PABP-3; poly A binding protein, cytoplasmic 1 pseudogene; poly(A) binding protein, cytoplasmic 3; poly(A) binding protein, cytoplasmic 6; poly(A)-binding protein 3; poly(A)-binding protein-like 3; Polyadenylate-binding protein 3; RP11-165I9.5; testis PABP; Testis-specific poly(A)-binding protein; testis-specific poly(A)-binding protein (PABP); testis-specific poly(A)-binding protein 3; unnamed protein product
基因别名: 4932702K14Rik; AI428050; PABP3; PABPC3; PABPL3; tPABP
UniProt ID: (Human) Q9H361
Entrez Gene ID: (Human) 5042, (Mouse) 67543, (Rat) 292295